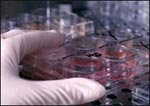

В России проведена первая операция по трансплантации стволовых клеток Успешная трансплантация стволовых клеток прошла в Центре детской онкологии и гематологии Областной детской клинической больницы №1 в Екатеринбурге.
Как сообщил департамент информационной политики губернатора региона, операция была проведена 30 октября, через 14 дней пересаженные стволовые клетки успешно прижились.
Трехлетняя Инга Черепанова, которой сентябре 2005 года врачи поставили диагноз: злокачественная опухоль с множественными отдаленными метастазами, после операции чувствует себя хорошо и продолжает лечение, необходимое для полного восстановления поврежденного костного мозга.
В сообщении департамента указывается, что подобная операция по "трансплантации кроветворных стволовых клеток была единственным способом, позволяющим вылечить Ингу".
Центр детской онкологии был открыт в феврале 2006 года. В настоящее время в нем проходят лечение 87 детей и подростков с различными злокачественными опухолями. С момента открытия, в лабораторном отделении внедрено более 10 передовых диагностических и исследовательских технологий, включая подбор родственных доноров костного мозга. Менее чем за год в центре было проведено 50 операций по хирургическому удалению опухолей, еще два ребенка готовятся к пересадке костного мозга.
В России Федеральная служба по надзору в сфере здравоохранения и социального развития впервые выдала разрешение на применение медицинской технологии с использованием стволовых клеток научно-исследовательскому лечебно-реабилитационному центру "Институт биологической медицины" в июне 2005 года.
По материалам NEWSru.com |